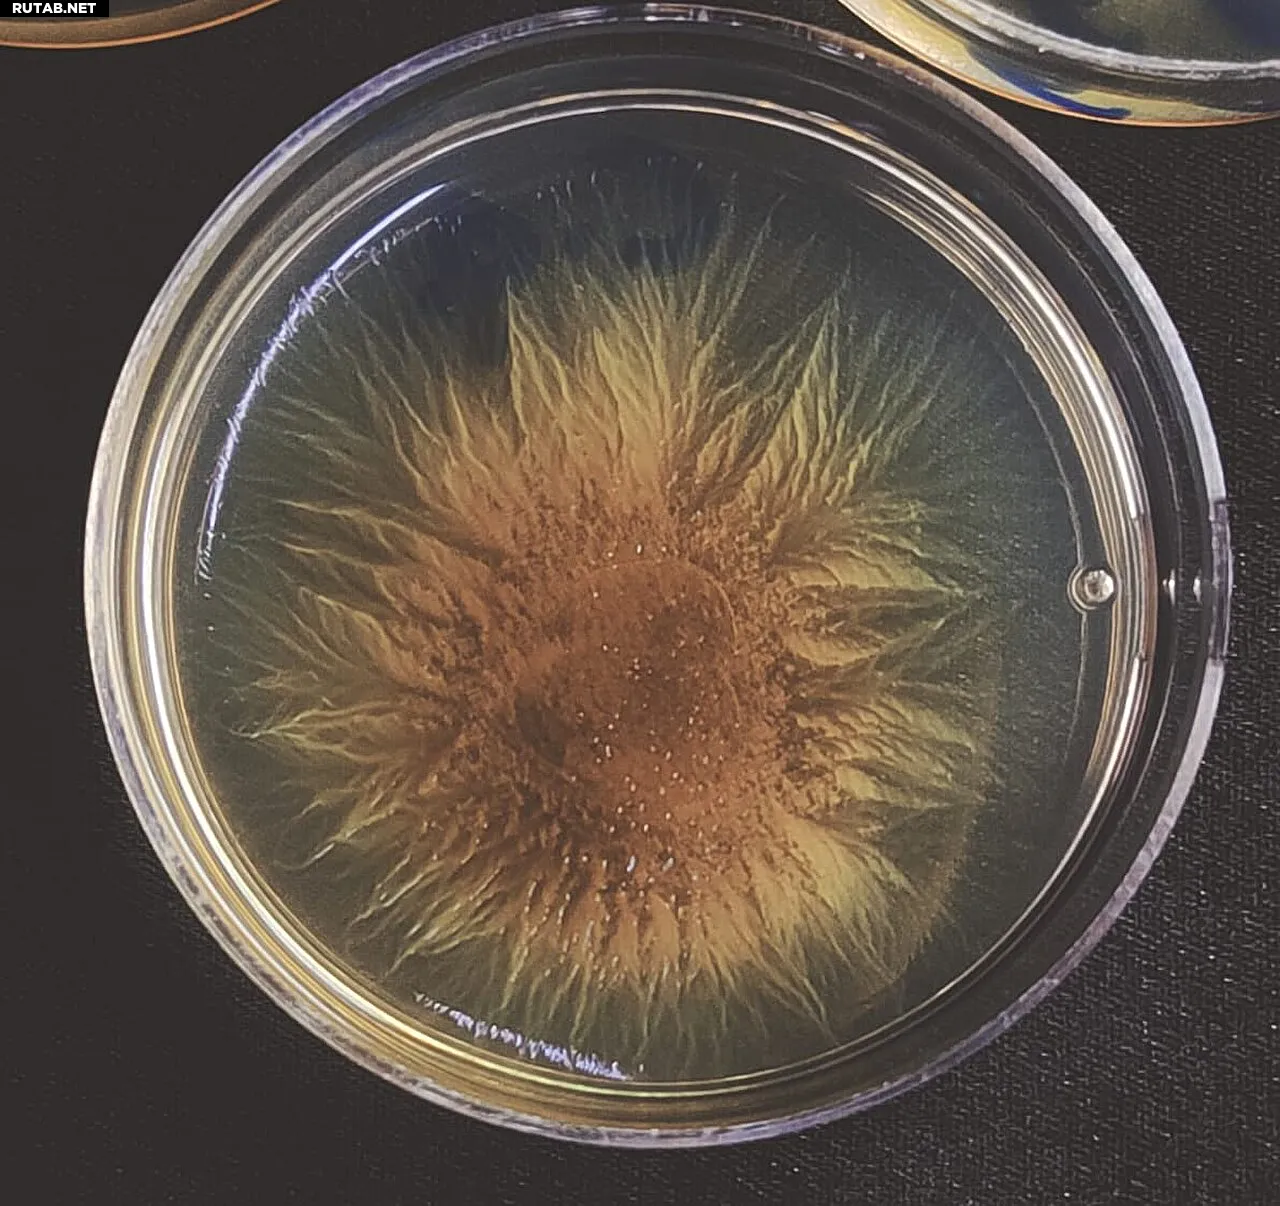

Как популяционные бутылочные горлышки влияют на кооперацию бактерий
Микробы часто демонстрируют кооперативное поведение, при котором отдельные клетки работают и жертвуют ресурсами на благо всей группы. Однако иногда «обманщики» в популяции могут пожинать плоды этой кооперации, не неся никаких затрат. Учёные предполагали, что в таких случаях популяционные бутылочные горлышки — резкое сокращение общего числа особей — могут помочь стабилизировать кооперативное поведение.
Рой бактерий M. xanthus на мягкой агаровой пластине. Автор: Джйотсна Калатера
Новое исследование, опубликованное в журнале PLOS Biology, показывает, что популяционные бутылочные горлышки могут коренным образом менять то, как кооперация развивается и сохраняется в сложных микробных сообществах.
Исследователи из Индийского института науки изучили, как повторяющиеся бутылочные горлышки влияют на кооперативные черты бактерии Myxococcus xanthus — модельного социального микроорганизма, известного своей удивительной способностью к скоординированной охоте и образованию спор внутри многоклеточных плодовых тел.
«Популяционное бутылочное горлышко — это резкое и внезапное сокращение как размера, так и разнообразия популяции. Если существуют способы очистить популяцию от обманщиков… это был бы один из идеальных способов сделать это», — говорит Джйотсна Калатера, бывшая аспирантка кафедры микробиологии и клеточной биологии и первый автор исследования.
«Наводнения и лесные пожары в дикой природе массово сокращают численность популяций. Когда мы говорим о макроэкосистемах растений, животных, медведей и тигров, проверить любую из этих гипотез сложно; приходится использовать более концептуальный подход, и для ответа на эти вопросы используют микроорганизмы», — объясняет Самай Панде, доцент кафедры и ответственный автор исследования.
Ключевые выводы о бутылочных горлышках и кооперации
С помощью долгосрочных экспериментов по эволюции команда сравнила популяции Myxococcus, подвергшиеся жёстким бутылочным горлышкам (когда в каждом последующем цикле выживает очень мало особей) и мягким (когда выживает больше). Эти условия искусственно создавались в лаборатории путём отбора определённого малого числа бактерий для культивирования в каждом следующем поколении.
В обоих условиях изучались четыре основные кооперативные черты: спорообразование, прорастание, хищничество и рост.
Команда обнаружила, что при жёстких бутылочных горлышках благоприятствовались образование плодовых тел и рост, тогда как хищничество и прорастание снижались, что приводило к появлению более однородных популяций кооперативных особей.
Напротив, мягкие бутылочные горлышки обращали эту тенденцию вспять, что приводило к общему увеличению конкурентной приспособленности или борьбы за ресурсы на протяжении всего жизненного цикла организма.
«В этом исследовании мы выяснили генетические изменения, связанные с тем, как жёсткие и мягкие бутылочные горлышки влияют на кооперативные черты, но мы ещё не раскрыли их молекулярную основу», — добавляет Панде.
Значение для микробной эволюции
Результаты углубляют наше понимание того, как популяционная динамика влияет на эволюцию микробных признаков, и предлагают новые взгляды на поддержание кооперации в естественных микробных сообществах.
«Кооперация необходима в контексте эволюции жизни. Множество генов должно работать вместе, чтобы сформировать хромосомы, а клеткам необходимо сотрудничать для создания многоклеточных организмов», — добавляет Панде.
Больше информации: Jyotsna Kalathera et al, Bottleneck size drives the evolution of cooperative traits in an aggregative multicellular myxobacterium, PLOS Biology (2026). DOI: 10.1371/journal.pbio.3003499.

0 комментариев